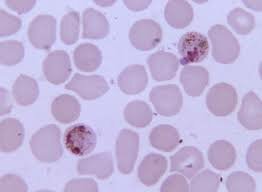
Laveran.

-
 Descripción probablemente de gusano Taenia saginata y tratamiento para eliminarlo.
Descripción probablemente de gusano Taenia saginata y tratamiento para eliminarlo. -
Asignó una clasificación a los gusanos intestinales y los denominó anchos, aplanados, cilíndricos y filiformes.
-
Hablo de diversos parásitos, sobre todo de gusanos intestinales del hombre y de algunos animales..
-
Habló de diversos parásitos, sobre todo de gusanos intestinales del hombre y de algunos animales.
-
 Descubrió de la Duela del hígado (Schistosoma).
Descubrió de la Duela del hígado (Schistosoma). -
 Describió el Botriocéfalo (Diphyllobothrium latum).
Describió el Botriocéfalo (Diphyllobothrium latum). -
Demostró que las cresas de las moscas nacían de los huevos puestos por ellas mismas y que incluso en los gusanos como los Áscaris, había machos y hembras que se reproducían a través de los huevos puestos por las hembras de la especie. Búsqueda sistemática de parásitos en animales domésticos y salvajes.
-
 Presento evidencias de que la generación espontanea no existe.
Presento evidencias de que la generación espontanea no existe. -
 1er Concepto de evolución.
1er Concepto de evolución. -
 Proponen la teoría celular.
Proponen la teoría celular. -
 Concepto alternancia de generaciones.
Concepto alternancia de generaciones. -
 Teoría de la herencia.
Teoría de la herencia. -
 Concepto de evolución.
Concepto de evolución. -
 Puso fin a la teoría de la generación espontanea.
Puso fin a la teoría de la generación espontanea. -
Descubrió el Hemosporidio (Plasmodium).
Descubrió el Hemosporidio (Plasmodium). -
 Describió que los mosquitos Anopheles actuaban como vectores del Plasmodium
Describió que los mosquitos Anopheles actuaban como vectores del Plasmodium
A list shows items. A timeline shows sequence.
Use Timetoast to make dates, milestones, and turning points easier to understand in a clear visual format. Timetoast is a timeline maker for work, school, research, and stories.